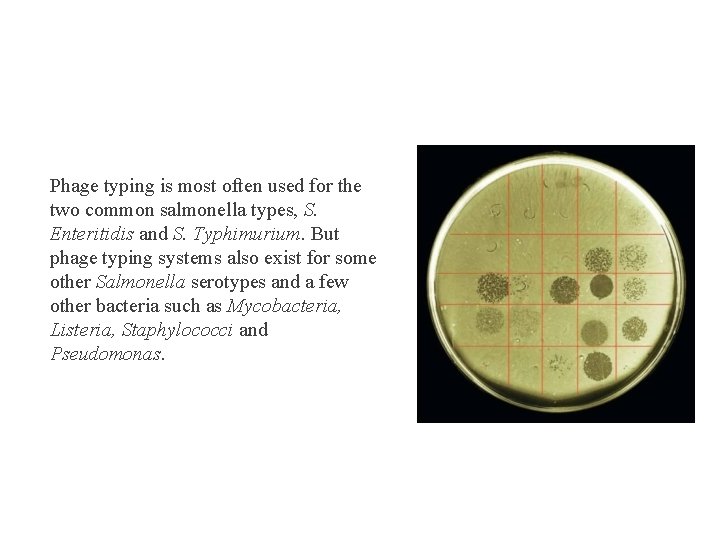
Phage typing is most often used for the two common salmonella types, S. Enteritidis

Bacteriophage Bacteriophage Phage were rst described in 1915

Bacteriophage

Bacteriophage Phage were first described in 1915 by Frederick Twort and 1917 by Felix d’Herelle. Both men discovered phage when the bacteria they were working with lysed. The agent responsible for the lysis was transferable from culture to culture, invisible by light microscopy, and would go through the smallest filter they had. d’Herelle coined the term “bacteriophage”, signifying an entity that eats bacteria. Bacteriophages or (phage) are viruses that recognize and target bacterial cells ) in order to replicate. The largest group is the Caudovirales, or tailed phages, that make up 96% of all phages. There at least 12 distinct groups of phages and each phage species is specific to its bacterial host.

Classification and Characteristics Bacteriophages occur abundantly in the biosphere, with different virions, genomes, and lifestyles. Over 5000 bacteriophage have been studied by electron microscope and can be divided in 13 viruses family. Properties: § Prokaryotes. § Obligate intracellular parasites. § Subcellular structure without metabolic machinery § Phages are classified according to morphology and nucleic acid. § They are typically highly specific, often being restricted to particular strains within a single bacterial species

Composition of bacteriophage Depending upon the phage, the nucleic acid can be either DNA or RNA but not both. The phage genome can be made of either double- or single-stranded DNA or RNA, and the genome can be circular or linear. More than 90% of bacteriophages have large, double-stranded DNA genomes located in heads with icosahedral symmetry, with tails of varying lengths. The nucleic acids of phages often contain unusual or modified bases, which protect phage nucleic acid from nucleases that break down host nucleic acids during phage infection. Simple phages may have only 3 -5 genes while complex phages may have over 100 genes. in For many phage types, the capsid is attached to a tail structure, and capsid surrounding the phage genome that are also made from phage-encoded proteins to protect the bacteriophage.

Structure of bacteriophage 1. Is prism like hexagonal. 2. Is the head tail connector consists of a collar or a disc and several whiskers. 3. Is the narrow cylindrical part. It has central hollow core or tube through which viral DNA is injected into the host. 4. : Is the hexagonal plate with tail fibres, usually 6 in number and used for attachment to the host cell wall during infection. Tail fibres can recognize specific receptor sites in the host cell wall.

Phages morphological groups A: (Myoviridae) Phage with elongated head and neck whiskers (Myoviridae) B: (Siphoviridae) Phage with flexible tail and tail fibers (Siphoviridae) C: (Podoviridae) Phage with icosahedral head and tail fibers

Types of bacteriophages 1. Lytic or virulent phage: Phage that can only multiply within bacteria and kill the cell by lysis. (e. g. , T 4). 2. Lysogenic or temperate phage: Phage that can either multiply via the lytic cycle or enter a quiescent state in the bacterial cell. (e. g. , Lambda )

Infection processes of T 4 1. Attachment to specific host bacterium and inserts its genetic material. 2. Bacterial chromosome is degraded. 3. Transcription by disrupting the bacterial genome and killing the bacterium. block bacterial DNA synthesis and degrade host chromosomal DNA block transcription of host m. RNAs block translation of host proteins small amounts of early proteins produced (catalytic functions) transcription from single phage genome

4. Replication that taking over the bacterial DNA and protein synthesis machinery to make phage components. 5. Assembly of new phage 6. Lysis of the bacterial cell wall to release hundreds of new copies of phage. Lytic cycle of phage

Lysogenic or Temperate Phage Lysogenic or temperate phages are those that can either multiply via the lytic cycle or enter a quiescent state in the cell. In most cases the phage DNA actually integrates into the host chromosome and is replicated along with the host chromosome and passed on to the daughter cells. Anytime a lysogenic bacterium is exposed to adverse conditions, the lysogenic state can be terminated. This process is called induction. Conditions which favor the termination of the lysogenic state include: desiccation, exposure to UV or ionizing radiation, exposure to mutagenic chemicals, etc. Adverse conditions lead to the production of proteases (rec A protein) which destroy the repressor protein. This in turn leads to the expression of the phage genes, reversal of the integration process and lytic multiplication.

Significance of Lysogeny Model for animal virus transformation Lysogeny is a model system for virus transformation of animal cells Lysogenic conversion When a cell becomes lysogenized, occasionally extra genes carried by the phage get expressed in the cell. These genes can change the properties of the bacterial cell. This process is called lysogenic or phage conversion. This can be of significance clinically. e. g. Lysogenic phages have been shown to carry genes that can modify the Salmonella O antigen, which is one of the major antigens to which the immune response is directed. Toxin production by Corynebacterium diphtheriae is mediated by a gene carried by a phage. Only those strain that have been converted by lysogeny are pathogenic. Gene transfer in bacteria Medical applications • Identification of bacteria - phage typing


Applications Phage typing • Phage typing is still used to identify and distinguish different strains within a given species when isolated from different origins (disease, food, water, environmental) or geographical locations. • In this method, phage dilutions are spotted onto a bacterial lawn; if bacteria are sensitive to the phage, bacterial lysis occurs resulting in an area of clearing. • Susceptibility of target bacteria to different phages leads to a characteristic pattern and enables the specific strain to be characterized and epidemiologically identified. • Phage typing schemes exist for the majority of clinically relevant pathogens including Brucella, Clostridium, Enterococci, Salmonella, Shigella, Listeria, toxigenic Escherichia coli, Campylobacter, Bacillus cereus, Vibrio cholerae, Mycobacterium tuberculosis, Proteus, Yersinia and Staphylococci.
Phage typing is most often used for the two common salmonella types, S. Enteritidis and S. Typhimurium. But phage typing systems also exist for some other Salmonella serotypes and a few other bacteria such as Mycobacteria, Listeria, Staphylococci and Pseudomonas.

Bacteriophage Typing of Salmonella Required bacterial cultures Salmonella strains for testing § Escherichica coli can be used as host for phage isolation. § Isolation of bacteriophages: bacteriophages can be isolated from different sources: animal fecal specimens, intestinal contents of poults infected with bluecomb, and carrier strains of Salmonella and Escherichia species. Testing for the presence of phages by performing the tube method or by the plate method. Plating done by using the semisolid agar (0. 5%) overlay method. Phage titers expressed as plaque-forming units (PFU) per milliliter.

Phages are tested for their ability to lyse the strains of Salmonella to be tested. Nutrient agar plates were dried overnight at 37 C. The plates were marked with their respective phage numbers. {control} Testing bacteria: about 2 to 3 ml of bacterial cultures is spread on the surface of agar plates. The inoculated plates were allowed to dry for 15 to 20 min. By means of a standard platinum loop, a drop of each phage preparation is placed on previously marked areas. The plates are allowed to dry for 30 min after which they are incubated at 37 C; and examined after 6 and 8 hr. Readings done by using a Quebec colony counter. The results of lytic activity recorded as follows: § no reaction(-) § any number of plaques (about 5 or more) or any degree of lysis (+).


Applications phage-based products Agri. Phage™ Targets bacterial spot or bacterial speck on crops, with specific formulations for strains of Xanthomonas campestris pv. vesicatoria or Pseudomonas syringae pv. Tomato Bio. Tector Animal feed for control of Salmonella in poultry Eco. Shield™ Targets Escherichia coli. O 157: H 7 contamination in foods and food processing facilities FASTPlaque-Response™ Rapid detection of rifampicin resistance in smear-positive sputum specimens containing M. tuberculosis FASTPlaque. TB™ Rapid detection of Mycobacterium tuberculosis in human sputum samples

List. Shield™ Targets Listeria monocytogenes contamination in foods and food processing facilities LISTEX™ P 100 A food processing aid that target s. L. Monocytogenes strains on food products MRSA/MSSA Blood culture test Determining of Staphylococcus aureus methicillin resistance or susceptibility directly from blood cultures MRSA Screening test Identifies methicillin-resistant. Staph. aureus(MRSA) for use in Infection Control programs Micro. Phage MRSA/MSSA test Differentiation of methicillin-resistant (MRSA) and methicillin-susceptible (MSSA)Staph. aureus

d n E e Th
- Slides: 20